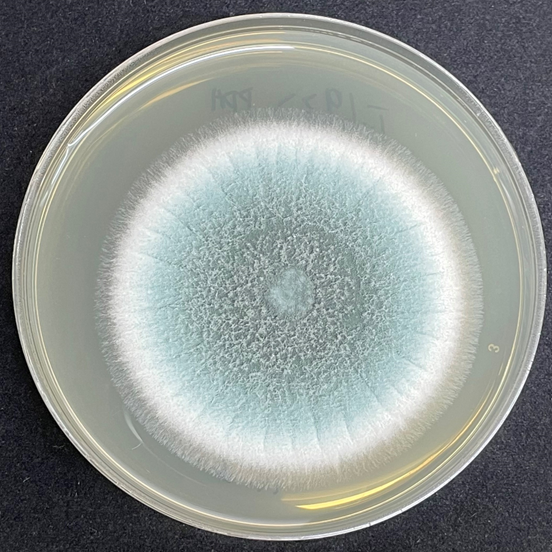
中招这种病菌,小心肺部“发霉”!这几类人群尤其要注意!

-

开学季破解分离焦虑 2025-08-29
开学季的幼儿园门口,总能听见此起彼伏的哭闹声——孩子拽住父母的衣角哭闹,不让父母离开,眼泪鼻涕糊了一脸;有的父母刚转身,孩子就坐在地上嚎啕大哭,喊着“我要妈妈”……这一幕,其实是儿童分离焦虑的典型表现...
-

这个吃饭习惯,可能让娃越来越胖! 2025-08-29
儿童肥胖已成为影响身心健康的重要问题,其防治需从日常饮食习惯入手。本文将介绍如何通过增加蔬菜摄入、优化家庭饮食环境以及进食方式,科学有效地帮助孩子预防肥胖,促进健康成长。一、多吃蔬菜真能预防儿童肥胖吗...
-

科学减重一起来 | 运动后大汗淋漓,需要补充电解质吗 2025-08-28
虽已立秋,但气温仍居高不下,减重人士经常在畅快运动后大汗淋漓。此时需要补充电解质吗?如果不补充,会出现电解质紊乱吗?今天我们来详细解答这些问题。电解质是指在水中能够解离出带电粒子的物质,主要包括钾离子...
-

家里有蚊子,这样做速战速决不挨咬! 2025-08-25
如何招御花斑蚊侵袭?预防基孔肯雅热必看!
-

开学季预防传染病5大要点!转发收藏! 2025-08-25
托幼机构和学校是儿童青少年聚集的场所,容易发生传染病的流行。开学季学生重点关注的传染病有以下几个方面,一是呼吸道传染病,包括流感、麻疹、风疹、腮腺炎、水痘、百日咳、肺结核等;二是肠道传染病,比如手足口...
-

不刷牙睡觉 VS 不刷牙吃早餐,哪个更伤身?答案出乎意料 2025-08-22
很多人有这样的生活经历,忙了一整天,结束了一天的打工生活,实在是没有力气再洗漱,倒头就睡;突然听到闹钟睁开惺忪的睡眼,哪有时间刷牙,因为下一秒已经抓起一块面包夺门而出。不刷牙睡觉和不刷牙就吃早餐,这两...
-

桶装水开封后能喝多久?牢记这四点,别让“清凉水”变成“细菌水”! 2025-08-22
当你畅饮一杯清凉的桶装水时是否想过这看似清澈安全的水源可能潜藏着看不见的健康威胁?温暖潮湿的环境正是微生物滋生的绝佳温床桶装水的微生物污染风险,不容忽视!水的“保质期”比你想象的短得多!桶装水包装上标...
-
中招这种病菌,小心肺部“发霉”!这几类人群尤其要注意! 2025-08-21
我们的环境中存在很多真菌,有一些真菌物种可对人类造成感染和引发疾病,且其释放的孢子能够借助空气传播。更令人担忧的是,气候变化可能进一步扩大其适宜传播的区域,增加感染风险。曲霉菌就是这类真菌的一种。那么...


 无障碍浏览
无障碍浏览
 长者浏览助手
长者浏览助手





